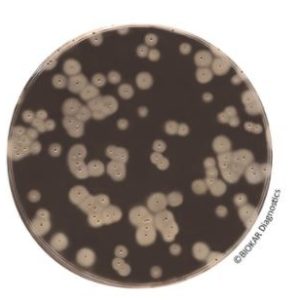
EASY STAPH - Agar (Kit)

EASY STAPH – Agar (Kit)
$0.00
Manufacturer: Biokar Diagnostics
CAT NO: BT01208
- Description
- Size Guide
- Vendor Info
- More Products
Description
EASY STAPH – Agar (Kit)
Product Description of EASY STAPH – Agar (Kit)
EASY STAPH is an alternative method for the enumeration of coagulase positive Staphylococci in food products, in animal feeds and in environmental samples. Devoid of the need for confirmation, the method allows count of pathogenic staphylococci in 22 hours instead of the usual 48 hours in the case of the standardized method NF EN ISO 6888-2. The media support the use of surface inoculation, in depth or by the Spiral method.
For all products destined for human consumption, the method is certified NF VALIDATION, under the Attestation N°BKR 23/10 – 12/15.
PACKAGING
EASY STAPH ready-to-use :
BM18708 – 20 Petri plates Ø 90 mm
BM19008 – 120 Petri plates Ø 90 mm
EASY STAPH KIT :
BT01208 – 6 vials of 190 mL of base media + 6 freeze-dried supplements
BT01308 – 6 vials of 90 mL of base media + 6 freeze-dried supplements